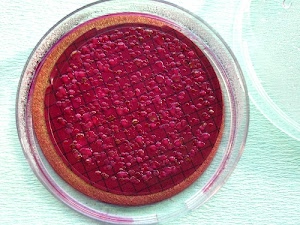

11° Giocattoli antichi Voto: 68.97 |  35° Anatroccoli infreddoliti Voto: 60.43 |
 89° Gattino Voto: 46.53 |  95° Pupazzetti Voto: 45.93 |
 125° Statua bambino Voto: 38.61 |  143° Casetta per uccelli Voto: 34.2 |
156° Più piccoli di così ... Voto: 29.3 |  157° Automobilina per bimbi ricchi Voto: 29.06 |
 160° Sella per bambini Voto: 26.1 |  164° Carrozza per figli dell'Imperatore Voto: 23.57 |